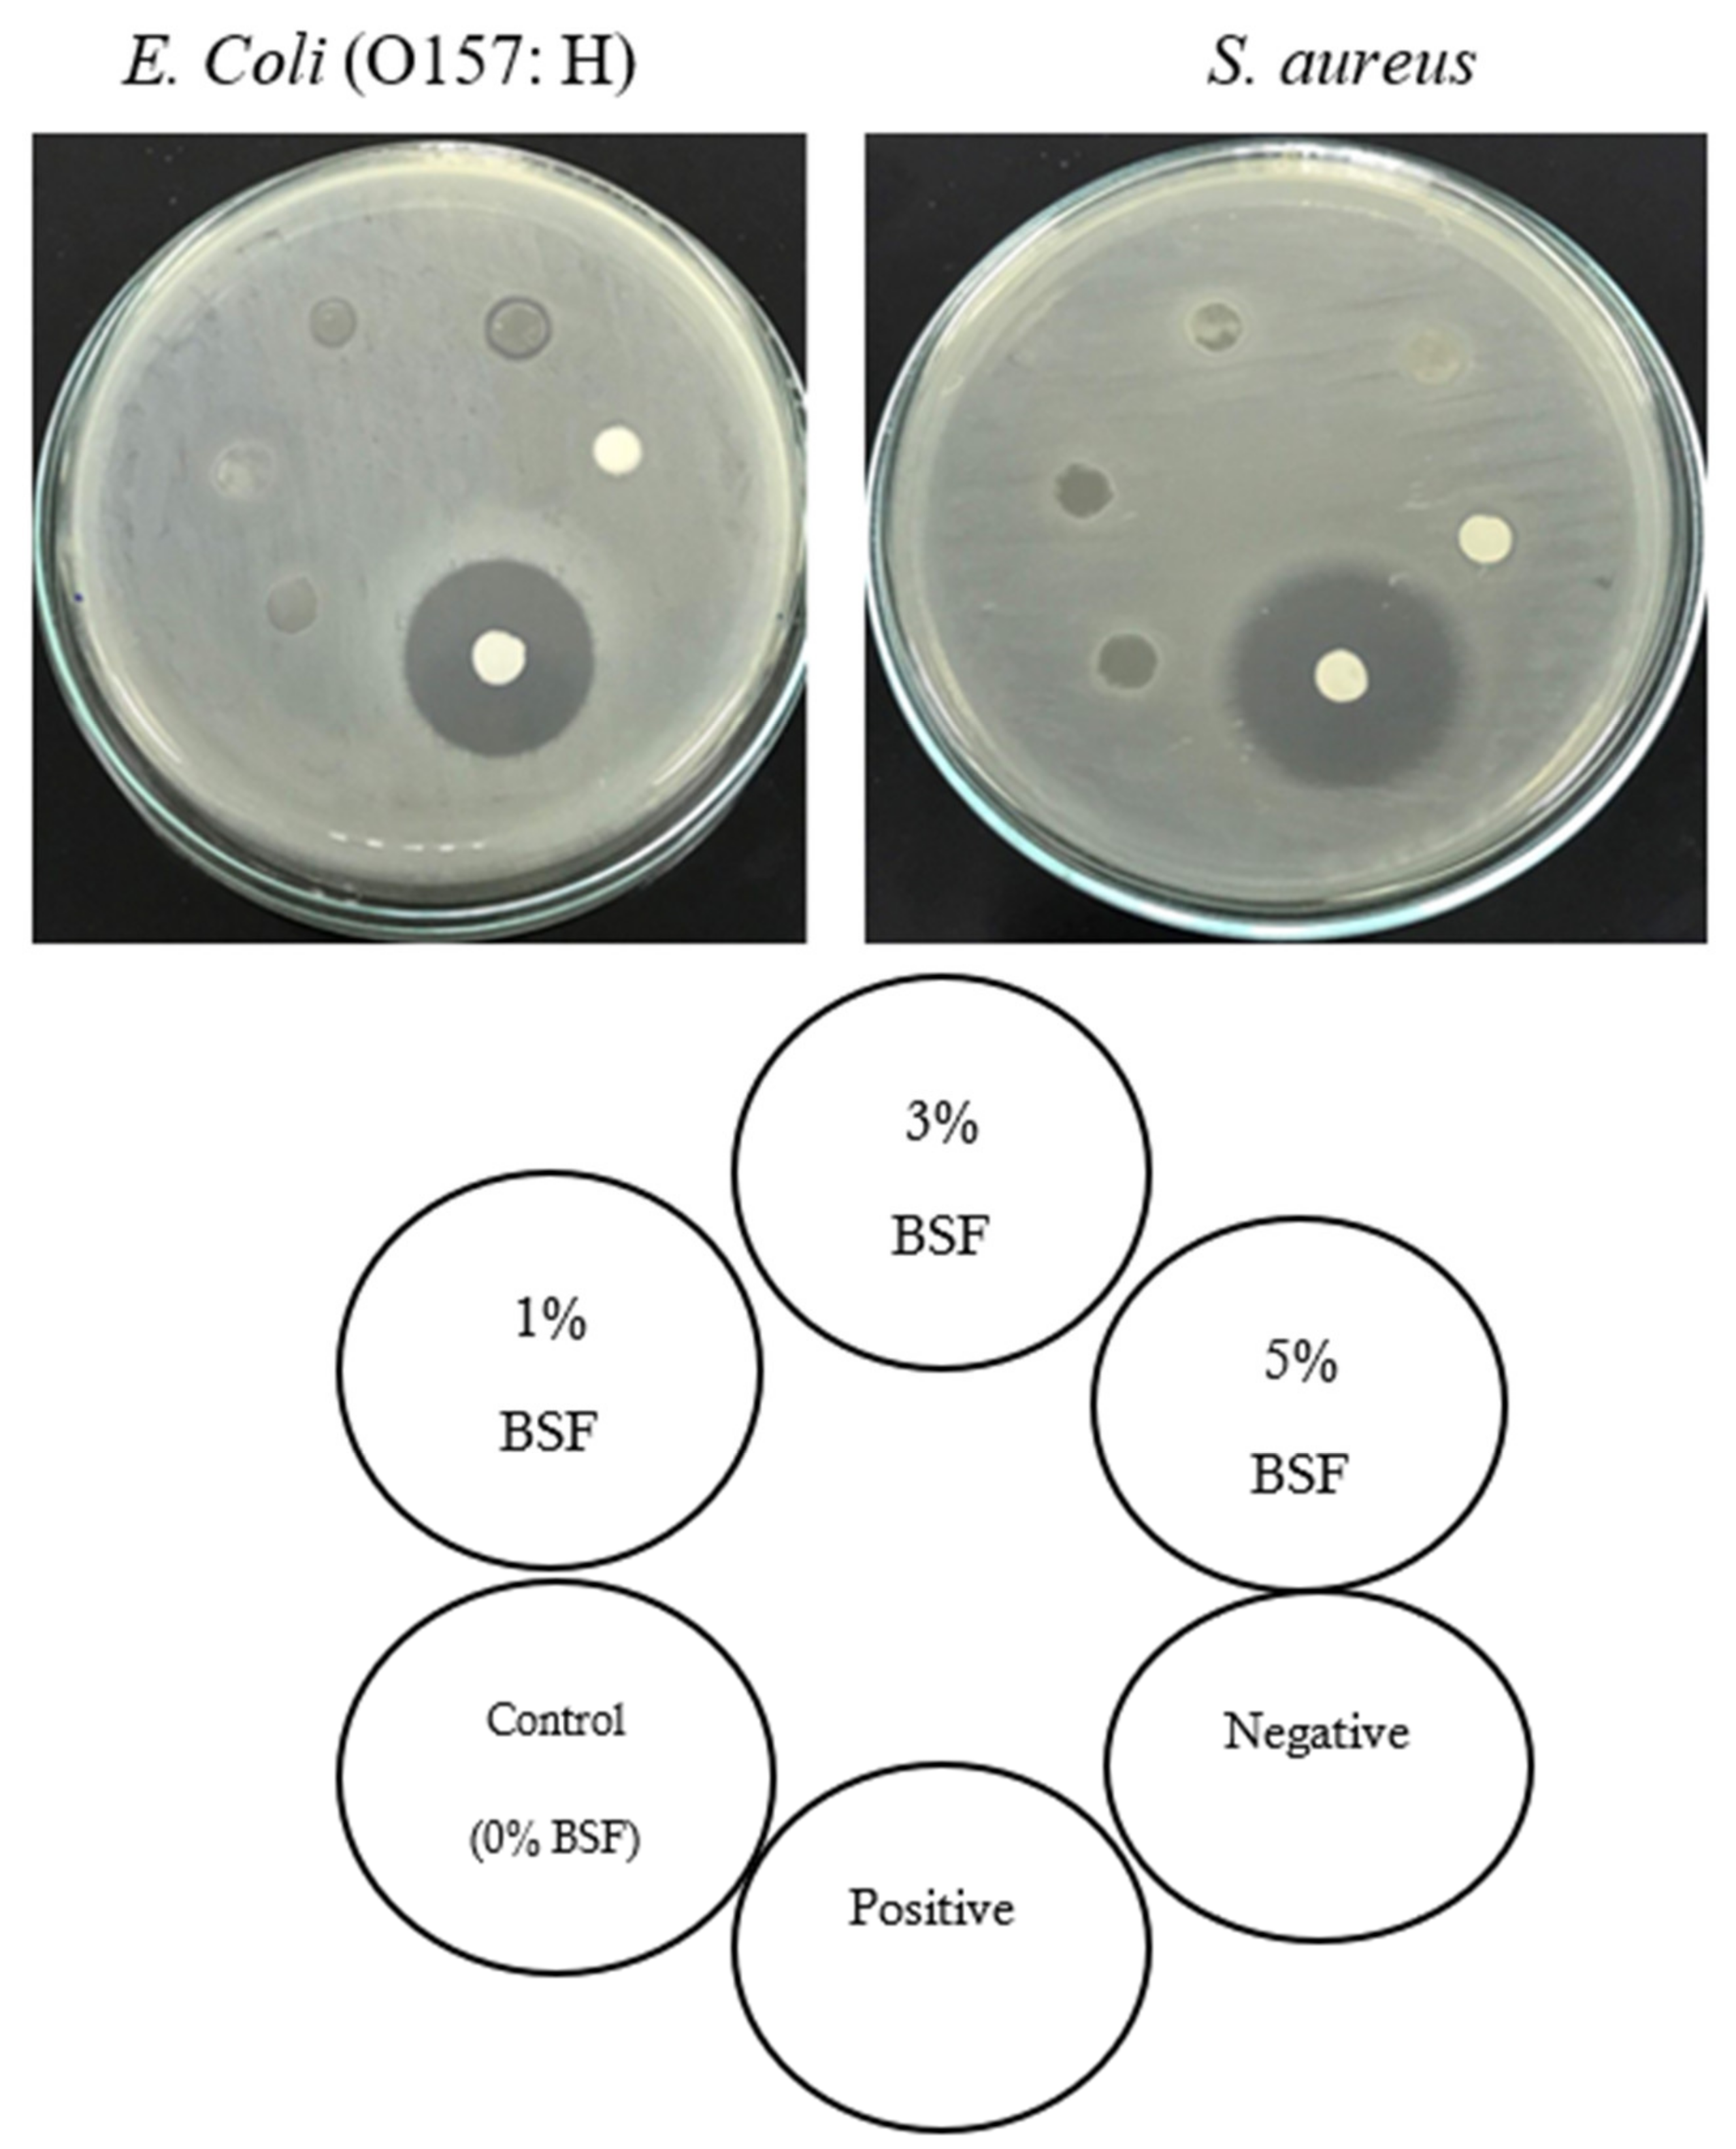

Properties of Banana (Cavendish spp.) Starch Film Incorporated with Banana Peel Extract and Its Application
Abstract
1. Introduction
2. Results and Discussion
2.1. Properties of Banana Starch Film Incorporated with Banana Peel Extract
2.1.1. Thickness
2.1.2. Mechanical Properties
2.1.3. Thermal Properties
2.1.4. Film Appearance and Color
2.1.5. Moisture Content, Film Solubility, Water Vapor Permeability
2.1.6. Antioxidant Properties of the Films
2.1.7. Light Transmission and Transparency
2.1.8. Antimicrobial Activity of the Films
2.2. Quality Attributes of Minced Pork Wrapped with Developed Banana Starch Film
2.2.1. Color Changes of Minced Pork during Storage
2.2.2. Weight Loss, TBARS and pH Changes of Minced Pork during Storage
2.2.3. Microbiological Quality of Minced Pork during Storage
3. Materials and Methods
3.1. Chemicals and Reagents
3.2. Sample Preparation
3.2.1. Banana Flour and Peel Powder Preparation
3.2.2. Banana Starch Preparation
3.2.3. Banana Peel Extraction
3.2.4. Preparation of Banana Starch Film
3.3. Banana Starch Film Characterization
3.3.1. Thickness
3.3.2. Color
3.3.3. Light Transmission and Transparency
3.3.4. Mechanical Properties
3.3.5. Differential Scanning Calorimetry
3.3.6. Moisture Content
3.3.7. Water Vapor Permeability
3.3.8. Film Solubility
3.3.9. Antioxidant Properties
3.3.10. Antimicrobial Activity
3.4. Application of the Banana Starch Films
3.5. Determinations of Quality of Minced Pork
3.5.1. Color
3.5.2. Weight Loss
3.5.3. PH Determination
3.5.4. Lipid Oxidation
3.5.5. Microbiological Quality
3.6. Statistical Analysis
4. Conclusions
Author Contributions
Funding
Institutional Review Board Statement
Informed Consent Statement
Data Availability Statement
Acknowledgments
Conflicts of Interest
Sample Availability
References
- Leceta, I.; Guerrero, P.; De la Caba, K. Functional properties of chitosan-based films. Carbohydr. Polym. 2013, 93, 339–346. [Google Scholar] [CrossRef] [PubMed]
- Sartori, T.; Menegalli, F.C. Development and characterization of unripe banana starch films incorporated with solid lipid microparticles containing ascorbic acid. Food Hydrocolloids 2016, 55, 210–219. [Google Scholar] [CrossRef]
- Cazón, P.; Velazquez, G.; Ramírez, J.A.; Vázquez, M. Polysaccharide-based films and coatings for food packaging: A re-view. Food Hydrocolloids 2017, 68, 136–148. [Google Scholar]
- Restrepo, A.E.; Rojas, J.D.; Garcia, O.R.; Sanchez, L.T.; Pinzon, M.I.; Villa, C.C. Mechanical, barrier, and color properties of banana starch edible films incorporated with nanoemulsions of lemongrass (Cymbopogon citratus) and rosemary (Ros-marinus officinalis) essential oils. Food Sci. Technol. Int. 2018, 24, 705–712. [Google Scholar] [CrossRef] [PubMed]
- Ramírez-Hernández, A.; Aparicio-Saguilán, A.; Reynoso-Meza, G.; Carrillo-Ahumada, J. Multi-objective optimization of process conditions in the manufacturing of banana (Musa paradisiaca L.) starch/natural rubber films. Carbohydr. Polym. 2017, 157, 1125–1133. [Google Scholar] [CrossRef]
- Pelissari, F.M.; Andrade-Mahecha, M.M.; Sobral, P.J.d.A.; Menegalli, F.C. Isolation and characterization of the flour and starch of plantain bananas (Musa paradisiaca). Starch-Stärke 2012, 64, 382–391. [Google Scholar] [CrossRef]
- Tibolla, H.; Pelissari, F.; Martins, J.; Lanzoni, E.; Vicente, A.; Menegalli, F.; Cunha, R. Banana starch nanocomposite with cellulose nanofibers isolated from banana peel by enzymatic treatment: In vitro cytotoxicity assessment. Carbohydr. Polym. 2019, 207, 169–179. [Google Scholar] [CrossRef] [PubMed]
- Nieto-Suaza, L.; Acevedo-Guevara, L.; Sánchez, L.T.; Pinzón, M.I.; Villa, C.C. Characterization of Aloe vera-banana starch composite films reinforced with curcumin-loaded starch nanoparticles. Food Struct. 2019, 22, 100131. [Google Scholar] [CrossRef]
- Mohapatra, D.; Mishra, S.; Sutar, N. Banana and its by-product utilisation: An overview. J. Sci. Ind. Res. 2010, 69, 323–329. [Google Scholar]
- Borges, C.; Maraschin, M.; Coelho, D.; Leonel, M.; Gomez, H.; Belin, M.; Diamante, M.; Amorim, E.; Gianeti, T.; Castro, G.; et al. Nutritional value and antioxidant compounds during the ripening and after domestic cooking of bananas and plantains. Food Res. Int. 2020, 132, 109061. [Google Scholar] [CrossRef]
- Orsuwan, A.; Sothornvit, R. Effect of banana and plasticizer types on mechanical, water barrier, and heat sealability of plasticized banana-based films. J. Food Process. Preserv. 2017, 42, e13380. [Google Scholar] [CrossRef]
- Kaur, L.; Dhull, S.B.; Kumar, P.; Singh, A. Banana starch: Properties, description, and modified variations - A review. Int. J. Biol. Macromol. 2020, 165, 2096–2102. [Google Scholar] [CrossRef]
- Nur Hanani, Z.A.; Abdullah, S. Development of green banana (Musa paradisiaca) as potential food packaging films and coatings. Int. J. Adv. Sci. 2016, 6, 88–91. [Google Scholar]
- Daudt, R.; Avena-Bustillos, R.; Williams, T.; Wood, D.; Külkamp-Guerreiro, I.; Marczak, L.; McHugh, T. Comparative study on properties of edible films based on pinhão (Araucaria angustifolia) starch and flour. Food Hydrocoll. 2016, 60, 279–287. [Google Scholar] [CrossRef]
- Chabuck, Z.A.G.; Al-Charrakh, A.H.; Hindi, N.K.K.; Hindi, S.K.K. Antimicrobial effect of aqueous banana peel extract, Iraq. Res. Gate. Pharm. Sci. 2013, 1, 73–75. [Google Scholar]
- Kapadia, S.P.; Pudakalkatti, P.S.; Shivanaikar, S. Detection of antimicrobial activity of banana peel (Musa paradisiaca L.) on Porphyromonas gingivalis and Aggregatibacter actinomycetemcomitans: An in vitro study. Contemp. Clin. Dent. 2015, 6, 496–499. [Google Scholar] [CrossRef]
- Zhang, W.; Li, X.; Jiang, W. Development of antioxidant chitosan film with banana peels extract and its application as coating in maintaining the storage quality of apple. Int. J. Biol. Macromol. 2020, 154, 1205–1214. [Google Scholar] [CrossRef] [PubMed]
- Kaewprachu, P.; Osako, K.; Benjakul, S.; Rawdkuen, S. Quality attributes of minced pork wrapped with catechin–lysozyme incorporated gelatin film. Food Packag. Shelf Life 2015, 3, 88–96. [Google Scholar] [CrossRef]
- Pattarasiriroj, K.; Kaewprachu, P.; Rawdkuen, S. Properties of rice flour-gelatine-nanoclay film with catechin-lysozyme and its use for pork belly wrapping. Food Hydrocoll. 2020, 107, 105951. [Google Scholar] [CrossRef]
- Gutiérrez, T.J.; Morales, N.J.; Tapia, M.S.; Pérez, E.; Famá, L. Corn starch 80:20 “waxy”: Regular, “native” and phos-phated, as bio-matrixes for edible films. Procedia Mater. Sci. 2015, 8, 304–310. [Google Scholar] [CrossRef]
- Pérez, E.; Segovia, X.; Tapia, M.S.; Schroeder, M. Native and cross-linked modified Dioscorea trifida (cush-cush yam) starches as bio-matrices for edible films. J. Cell. Plast. 2012, 48, 545–556. [Google Scholar] [CrossRef]
- Gutiérrez, T.J.; Álvarez, K. Physico-chemical properties and in vitro digestibility of edible films made from plantain flour with added Aloe vera gel. J. Funct. Foods 2016, 26, 750–762. [Google Scholar] [CrossRef]
- Kaewprachu, P.; Rungraeng, N.; Osako, K.; Rawdkuen, S. Properties of fish myofibrillar protein film incorporated with catechin-Kradon extract. Food Packag. Shelf Life 2017, 13, 56–65. [Google Scholar] [CrossRef]
- Gutiérrez, T.J.; Suniaga, J.; Monsalve, A.; García, N.L. Influence of beet flour on the relationship surface-properties of edible and intelligent films made from native and modified plantain flour. Food Hydrocoll. 2016, 54, 234–244. [Google Scholar] [CrossRef]
- Verbeek, C.J.R.; Bier, J.M. Synthesis and characterization of thermoplastic agro-polymers. In Handbook of Applied Biopolymer Technology; Sharma, S.K., Mudhoo, A., Eds.; RSC Publishing: Cambridge, UK, 2011; pp. 197–242. [Google Scholar]
- Ma, X.; Jian, R.; Chang, P.R.; Yu, J. Fabrication and characterization of citric ccid-modified ctarch nanoparti-cles/plasticized-xtarch composites. Biomacromolecules 2008, 9, 3314–3320. [Google Scholar] [CrossRef]
- Orsuwan, A.; Shankar, S.; Wang, L.-F.; Sothornvit, R.; Rhim, J.-W. Preparation of antimicrobial agar/banana powder blend films reinforced with silver nanoparticles. Food Hydrocoll. 2016, 60, 476–485. [Google Scholar] [CrossRef]
- Wu, C.-H.; Huang, S.-M.; Lin, J.-A.; Yen, G.-C. Inhibition of advanced glycation endproduct formation by foodstuffs. Food Funct. 2011, 2, 224–234. [Google Scholar] [CrossRef]
- Benjakul, S.; Visessanguan, W.; Phongkanpai, V.; Tanaka, M. Antioxidative activity of caramelisation products and their preventive effect on lipid oxidation in fish mince. Food Chem. 2005, 90, 231–239. [Google Scholar] [CrossRef]
- Dave, D.; Ghaly, A.E. Meat Spoilage Mechanisms and Preservation Techniques: A Critical Review. Am. J. Agric. Biol. Sci. 2011, 6, 486–510. [Google Scholar] [CrossRef]
- Zhang, P.; Whistler, R.L.; Bemiller, J.N.; Hamaker, B.R. Banana starch: Production, physicochemical properties, and digestibility - A review. Carbohydr. Polym. 2005, 59, 443–458. [Google Scholar] [CrossRef]
- Alves, L.A.A.D.S.; Lorenzo, J.M.; Gonçalves, C.A.A.; Dos Santos, B.A.; Heck, R.T.; Cichoski, A.J.; Campagnol, P.C.B. Production of healthier bologna type sausages using pork skin and green banana flour as a fat replacers. Meat Sci. 2016, 121, 73–78. [Google Scholar] [CrossRef]
- Salama, Z.H. Identification of phenolic compounds from banana peel (Musa paradaisica L.) as antioxidant and antimicrobial agents. J. Chem. Pharm. Res. 2016, 8, 46–55. [Google Scholar]
- Rhim, J.-W.; Wang, L.-F. Mechanical and water barrier properties of agar/κ-carrageenan/konjac glucomannan ternary blend biohydrogel films. Carbohydr. Polym. 2013, 96, 71–81. [Google Scholar] [CrossRef] [PubMed]
- Tongnuanchan, P.; Benjakul, S.; Prodpran, T. Properties and antioxidant activity of fish skin gelatin film incorporated with citrus essential oils. Food Chem. 2012, 134, 1571–1579. [Google Scholar] [CrossRef] [PubMed]
- Herring, J.L.; Jonnalongadda, S.C.; Narayanan, V.C.; Coleman, S.M. Oxidative stability of gelatin coated pork at refrigerated storage. Meat Sci. 2010, 85, 651–656. [Google Scholar] [CrossRef] [PubMed]
- Buege, J.A.; Aust, S.D. Microsomal lipid peroxidation. Methods Enzymol. 1978, 52, 302–310. [Google Scholar]
- Siripatrawan, U.; Noipha, S. Active film from chitosan incorporating green tea extract for shelf life extension of pork sausages. Food Hydrocoll. 2012, 27, 102–108. [Google Scholar] [CrossRef]

| BSF with Banana Peel Extract | Thickness | Tensile Strength (TS) | Elongation at Break (EAB) | Thermal Properties | |
|---|---|---|---|---|---|
| (%, w/v) | (mm) | (MPa) | (%) | Tm (°C) | ΔH (J/g) |
| Control (0) | 0.030 ± 0.004 b | 31.20 ± 0.54 b | 15.63 ± 2.66 b | 95.50 ± 2.89 b | 273.90 ± 8.32 a |
| 1 | 0.048 ± 0.004 a | 4.43 ± 0.69 d | 9.66 ± 2.09 b | 89.83 ± 0.00 c | 219.70 ± 3.53 c |
| 3 | 0.048 ± 0.004 a | 5.28 ± 0.22 c | 11.34 ± 0.49 b | 97.61 ± 0.10 ab | 263.60 ± 3.17 b |
| 5 | 0.047 ± 0.003 a | 4.48 ± 0.11 d | 12.16 ± 0.93 b | 98.50 ± 0.00 a | 192.30 ± 4.83 d |
| PVC | 0.010 ± 0.00 c | 44.10 ± 0.28 a | 238.75 ± 22.30 a | ND * | ND |
| BSF with Banana Peel Extract (%, w/v) | Moisture Content (%) | Film Solubility (%) | WVP (× 10−10g mm/sm2 Pa) | DPPH Scavenging Activity (%) |
|---|---|---|---|---|
| Control (0) | 26.3 ± 3.24 b | 26.3 ± 1.68 c | 3.74 ± 0.97 b | 66.40 ± 1.04 c |
| 1 | 27.7 ± 2.97 b | 33.2 ± 3.97 b | 9.56 ± 0.47 a | 67.30 ± 0.98 c |
| 3 | 29.1 ± 1.41 ab | 38.9 ± 2.50 ab | 9.96 ± 0.74 a | 77.00 ± 1.63 b |
| 5 | 33.7 ± 2.65 a | 40.8 ± 4.75 a | 11.0 ± 1.62 a | 97.90 ± 5.42 a |
| PVC | ND * | ND | 1.15 ± 0.09 c | ND |
| BSF with Banana Peel Extract (%, w/v) | Transmittance (%T) at Wavelength (nm) | Transparency * | |||||||
|---|---|---|---|---|---|---|---|---|---|
| 200 | 280 | 350 | 400 | 500 | 600 | 700 | 800 | ||
| Control (0) | 27.1 | 46.9 | 48.8 | 49.1 | 49.3 | 49.6 | 50.4 | 51.7 | 3.23 ± 0.02 b |
| 1 | 24.3 | 40.5 | 41.3 | 42.6 | 42.8 | 43.1 | 43.4 | 44.5 | 2.97 ± 0.04 c |
| 3 | 21.6 | 31.5 | 32.4 | 32.6 | 33.6 | 33.7 | 33.8 | 35.0 | 2.85 ± 0.01 d |
| 5 | 18.9 | 30.5 | 31.7 | 31.9 | 32.5 | 33.0 | 33.6 | 34.2 | 2.85 ± 0.02 d |
| PVC | 12.1 | 84.8 | 87.9 | 89.5 | 90.3 | 91.3 | 91.6 | 91.9 | 3.95 ± 0.00 a |
| Storage Time (Days) | Film Wrap | L* | a* | b* | ΔE |
|---|---|---|---|---|---|
| 0 | BSF | 42.8 ± 0.62 g | 5.42 ± 0.26 a | 7.03 ± 0.63 f | - |
| PVC | 42.8 ± 0.62 g | 5.42 ± 2.56 a | 7.03 ± 0.63 f | - | |
| 1 | BSF | 47.5 ± 1.35 f | 4.42 ± 0.11 bc | 7.96 ± 0.33 ef | 5.79 ± 2.35 e |
| PVC | 50.9 ± 0.50 e | 4.85 ± 0.60 ab | 8.30 ± 0.41 ef | 9.14 ± 1.22 d | |
| 3 | BSF | 51.2 ± 1.10 e | 3.88 ± 0.33 cd | 9.83 ± 0.91 cd | 9.11 ± 1.66 d |
| PVC | 54.4 ± 1.23 cd | 4.26 ± 0.39 c | 8.89 ± 0.47 de | 11.8 ± 1.72 cd | |
| 5 | BSF | 53.5 ± 1.43 d | 3.50 ± 0.06 de | 10.7 ± 0.83 bc | 11.5 ± 1.59 cd |
| PVC | 56.3 ± 1.40 b | 3.85 ± 0.25 cd | 11.4 ± 1.30 b | 14.4 ± 1.35 b | |
| 7 | BSF | 55.6 ± 0.73 bc | 2.97 ± 0.11 e | 11.7 ± 0.88 ab | 13.9 ± 0.93 bc |
| PVC | 60.6 ± 0.50 a | 3.48 ± 0.44 de | 12.9 ± 0.38 a | 18.8 ± 0.60 a |
| Storage Time (Days) | Film | Total Plate Count (log CFU/g) | Yeast and Molds (log CFU/g) |
|---|---|---|---|
| 0 | BSF | 2.68 ± 0.03 a | 2.27 ± 0.09 a |
| PVC | 2.68 ± 0.23 a | 2.27 ± 0.09 a | |
| 1 | BSF | 3.72 ± 0.04 b | 2.55 ± 0.18 a |
| PVC | 2.99 ± 0.03 a | 2.36 ± 0.11 a | |
| 3 | BSF | 3.89 ± 0.03 a | 2.79 ± 0.08 a |
| PVC | 3.72 ± 0.04 b | 2.55 ± 0.09 b | |
| 5 | BSF | 4.04 ± 0.02 a | 2.82 ± 0.11 a |
| PVC | 3.83 ± 0.06 b | 2.63 ± 0.16 a | |
| 7 | BSF | 4.14 ± 0.02 a | 2.90 ± 0.02 a |
| PVC | 4.07 ± 0.01 b | 2.79 ± 0.09 a |
Publisher’s Note: MDPI stays neutral with regard to jurisdictional claims in published maps and institutional affiliations. |
© 2021 by the authors. Licensee MDPI, Basel, Switzerland. This article is an open access article distributed under the terms and conditions of the Creative Commons Attribution (CC BY) license (http://creativecommons.org/licenses/by/4.0/).
Share and Cite
Taweechat, C.; Wongsooka, T.; Rawdkuen, S. Properties of Banana (Cavendish spp.) Starch Film Incorporated with Banana Peel Extract and Its Application. Molecules 2021, 26, 1406. https://doi.org/10.3390/molecules26051406
Taweechat C, Wongsooka T, Rawdkuen S. Properties of Banana (Cavendish spp.) Starch Film Incorporated with Banana Peel Extract and Its Application. Molecules. 2021; 26(5):1406. https://doi.org/10.3390/molecules26051406
Chicago/Turabian StyleTaweechat, Chanitda, Tipapon Wongsooka, and Saroat Rawdkuen. 2021. "Properties of Banana (Cavendish spp.) Starch Film Incorporated with Banana Peel Extract and Its Application" Molecules 26, no. 5: 1406. https://doi.org/10.3390/molecules26051406
APA StyleTaweechat, C., Wongsooka, T., & Rawdkuen, S. (2021). Properties of Banana (Cavendish spp.) Starch Film Incorporated with Banana Peel Extract and Its Application. Molecules, 26(5), 1406. https://doi.org/10.3390/molecules26051406

